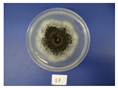
Applsci 11 08277 i001
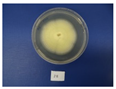
Applsci 11 08277 i002
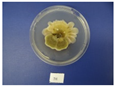
Applsci 11 08277 i003
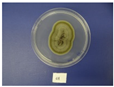
Applsci 11 08277 i005
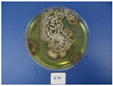
Applsci 11 08277 i007
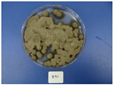
Applsci 11 08277 i009
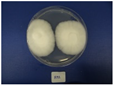
Applsci 11 08277 i010

The Presence of Marine Filamentous Fungi on a Copper-Based Antifouling Paint
Abstract
:1. Introduction
2. Materials and Methods
2.1. Antifouling Paint and Other Substrata
2.2. Experiment and Testing Site
2.3. Isolation of Fungi
2.4. Identification of Fungi
2.5. Copper Resistance of Fungal Isolates
3. Results and Discussion
3.1. Biofouling on Different Substrata
3.2. Species of Fungi Isolated from Different Substrata
3.3. Copper Resistance of Fungal Isolates
3.4. Importance of This Study
Supplementary Materials
Author Contributions
Funding
Institutional Review Board Statement
Informed Consent Statement
Data Availability Statement
Acknowledgments
Conflicts of Interest
References
- Wahl, M. Marine epibiosis. I. Fouling and antifouling: Some basic aspects. Mar. Ecol. Prog. Ser. 1989, 58, 175–189. [Google Scholar] [CrossRef] [Green Version]
- Dobretsov, S.; Dahms, H.-U.; Qian, P.-Y. Inhibition of biofouling by marine microorganisms and their metabolites. Biofouling 2006, 22, 43–54. [Google Scholar] [CrossRef] [PubMed]
- Salta, M.; Wharton, J.A.; Blache, Y.; Stokes, K.R.; Briand, J.-F. Marine biofilms on artificial surfaces: Structure and dynamics. Environ. Microbiol. 2013, 15, 2879–2893. [Google Scholar] [CrossRef] [PubMed]
- Hadfield, M.G. Biofilms and marine invertebrate larvae: What bacteria produce that larvae use to choose settlement sites. Annu. Rev. Mar. Sci. 2011, 3, 453–470. [Google Scholar] [CrossRef]
- Venkatesan, R.; Murthy, P.S. Macrofouling control in power plants. In Marine and Industrial Biofouling; Flemming, H.C., Murthy, P.S., Venkatesan, R., Cooksey, K., Eds.; Springer Series on Biofilms; Springer: Berlin/Heidelberg, Germany, 2009; Volume 4, pp. 1–27. [Google Scholar]
- Wieczorek, S.K.; Todd, C.D. Inhibition and facilitation of settlement of epifaunal marine invertebrate larvae by microbial biofilm cues. Biofouling 1998, 12, 81–118. [Google Scholar] [CrossRef]
- Dobretsov, S.; Rittschof, D. Love at first taste: Induction of larval settlement by marine microbes. Int. J. Mol. Sci. 2020, 21, 731. [Google Scholar] [CrossRef] [Green Version]
- Schultz, M.P.; Bendick, J.A.; Holm, E.R.; Hertel, W.M. Economic impact of biofouling on a naval surface ship. Biofouling 2011, 27, 87–98. [Google Scholar] [CrossRef]
- Yebra, D.M.; Kiil, S.; Dam-Johansen, K. Antifouling technology—Past, present and future steps towards efficient and environmentally friendly antifouling coatings. Prog. Org. Coat. 2004, 50, 75–104. [Google Scholar] [CrossRef]
- Bott, T.R. Biofouling control in cooling water. Int. J. Chem. Eng. 2009, 2009. [Google Scholar] [CrossRef] [Green Version]
- Jones, G. The battle against marine biofouling: A historical review. In Advances in Marine Antifouling Coatings and Technologies; Hellio, C., Yebra, D., Eds.; Woodhead publishing series in metals and surface engineering; CRC Press: Boca Ration, FL, USA, 2009; pp. 19–45. [Google Scholar]
- Maréchal, J.-P.; Hellio, C. Challenges for the development of new non-toxic antifouling solutions. Int. J. Mol. Sci. 2009, 10, 4623–4637. [Google Scholar] [CrossRef] [Green Version]
- Dempsey, M.J. Colonisation of antifouling paints by marine bacteria. Bot. Mar. 2009, 24, 185–192. [Google Scholar] [CrossRef]
- Thomas, T.E.; Robinson, M.G. The role of bacteria in the metal tolerance of the fouling diatom Amphora coffeaeformis Ag. J. Exp. Mar. Biol. Ecol. 1987, 107, 291–297. [Google Scholar] [CrossRef]
- Yang, J.-L.; Li, Y.-F.; Liang, X.; Guo, X.-P.; Ding, D.W.; Zhang, D.; Zhou, S.; Bao, W.-Y.; Bellou, N.; Dobretsov, S. Silver nanoparticles impact biofilm communities and mussel settlement. Sci. Rep. 2016, 6, 37406. [Google Scholar] [CrossRef] [Green Version]
- Yang, J.-L.; Li, Y.-F.; Guo, X.-P.; Liang, X.; Xu, Y.-F.; Ding, D.-W.; Bao, W.-Y.; Dobretsov, S. The effect of carbon nanotubes and titanium dioxide incorporated in PDMS on biofilm community composition and subsequent mussel plantigrade settlement. Biofouling 2016, 32, 763–777. [Google Scholar] [CrossRef]
- Chen, C.-L.; Maki, J.S.; Rittschof, D.; Teo, S.L.-M. Early marine bacterial biofilm on a copper-based antifouling paint. Int. Biodeterior. Biodegrad. 2013, 83, 71–76. [Google Scholar] [CrossRef]
- Pelletier, É.; Bonnet, C.; Lemarchand, K. Biofouling growth in cold estuarine waters and evaluation of some chitosan and copper anti-fouling paints. Int. J. Mol. Sci. 2009, 10, 3209–3223. [Google Scholar] [CrossRef] [Green Version]
- Winfield, M.O.; Downer, A.; Longyer, J.; Dale, M.; Barker, G.L.A. Comparative study of biofilm formation on biocidal antifouling and fouling-release coatings using next-generation DNA sequencing. Biofouling 2018, 34, 464–477. [Google Scholar] [CrossRef]
- Briand, J.-F.; Djeridi, I.; Jamet, D.; Cope, S.; Bressy, C.; Molmeret, M.; Le Berre, B.; Rimet, F.; Bouchez, A.; Blache, Y. Pioneer marine biofilms on artificial surfaces including antifouling coatings immersed in two contrasting French Mediterranean coast sites. Biofouling 2012, 28, 453–463. [Google Scholar] [CrossRef] [PubMed]
- Muthukrishnan, T.; Abed, R.M.M.; Dobretsov, S.; Kidd, B.; Finnie, A.A. Long-term microfouling on commercial biocidal fouling control coatings. Biofouling 2014, 30, 1155–1164. [Google Scholar] [CrossRef]
- Richards, T.A.; Leonard, G.; Mahé, F.; del Campo, J.; Romac, S.; Jones, M.D.M.; Maguire, F.; Dunthorn, M.; De Vargas, C.; Massana, R.; et al. Molecular diversity and distribution of marine fungi across 130 European environmental samples. Proc. R. Soc. B Biol. Sci. 2015, 282, 20152243. [Google Scholar] [CrossRef] [PubMed]
- Tisthammer, K.H.; Cobian, G.M.; Amend, A.S. Global biogeography of marine fungi is shaped by the environment. Fung. Ecol. 2016, 19, 39–46. [Google Scholar] [CrossRef]
- Overy, P.D.; Rämä, T.; Oosterhuis, R.; Walker, K.A.; Pang, K.-L. The neglected marine fungi, sensu stricto, and their isolation for natural products’ discovery. Mar. Drug. 2019, 17, 42. [Google Scholar] [CrossRef] [PubMed] [Green Version]
- Miao, L.; Qian, P.-Y. Antagonistic antimicrobial activity of marine fungi and bacteria isolated from marine biofilm and seawaters of Hong Kong. Aquat. Microb. Ecol. 2005, 38, 231–238. [Google Scholar] [CrossRef]
- Kirstein, I.V.; Wichels, A.; Krohne, G.; Gerdts, G. Mature biofilm communities on synthetic polymers in seawater-specific or general? Mar. Environ. Res. 2018, 142, 147–154. [Google Scholar] [CrossRef] [PubMed]
- Corcoll, N.; Yang, J.; Backhaus, T.; Zhang, X.; Eriksson, K.M. Copper affects composition and functioning of microbial communities in marine biofilms at environmentally relevant concentrations. Front. Microb. 2019, 9, 3248. [Google Scholar] [CrossRef]
- Lotlikar, N.; Damare, S.; Meena, R.M.; Jayachandran, S. Variable protein expression in marine-derived filamentous fungus Penicillium chrysogenum in response to varying copper concentrations and salinity. Metallomics 2020, 12, 1083–1093. [Google Scholar] [CrossRef] [PubMed]
- Interspeed BRA640 Red Safety Sheet. Available online: http://datasheets1.international-coatings.com/msds/BRA640_USA_eng_B4.pdf (accessed on 22 July 2020).
- Valkirs, A.O.; Seligman, P.F.; Haslbeck, E.; Caso, J.S. Measurement of copper release rates from antifouling paint under laboratory and in situ conditions: Implications for loading estimation to marine water bodies. Mar. Poll. Bull. 2003, 46, 763–779. [Google Scholar] [CrossRef]
- Jupp, B.P.; Fowler, S.W.; Dobretsov, S.; van der Wiele, H.; Al-Ghafri, A. Assessment of heavy metal and petroleum hydrocarbon contamination in the Sultanate of Oman with emphasis on harbours, marinas, terminals and ports. Mar. Pollut. Bull. 2017, 121, 260–273. [Google Scholar] [CrossRef]
- Muthukrishnan, T.; Dobretsov, S.; De Stefano, M.; Abed, R.M.M.; Kidd, B.; Finnie, A.A. Diatom communities on commercial biocidal fouling control coatings after one year of immersion in the marine environment. Mar. Environ. Res. 2017, 129, 102–112. [Google Scholar] [CrossRef]
- Al-Sadi, A.M.; Al-Mazroui, S.S.; Phillips, A.J.L. Evaluation of culture-based techniques and 454 pyrosequencing for the analysis of fungal diversity in potting media and organic fertilizers. J. Appl. Microb. 2015, 119, 500–509. [Google Scholar] [CrossRef]
- Al-Sadi, A.M.; Al-Ghaithi, A.G.; Al-Balushi, Z.M.; Al-Jabri, A.H. Analysis of diversity in Pythium aphanidermatum populations from a single greenhouse reveals phenotypic and genotypic changes over 2006 to 2011. Plant Dis. 2012, 96, 852–858. [Google Scholar] [CrossRef] [Green Version]
- White, T.J.; Bruns, T.D.; Lee, S.; Taylor, J. Amplification and direct sequencing of fungal ribosomal RNA genes for phylogenetics. In PCR Protocols: A Guide to Methods and Applications; Innis, M.A., Gelfand, D.H., Sninsky, J.J., White, T.J., Eds.; Academic Press: New York, NY, USA, 1990; pp. 315–322. [Google Scholar]
- Tamura, K.; Stecher, G.; Peterson, D.; Filipski, A.; Kumar, S. MEGA6: Molecular evolutionary genetics analysis version 6.0. Mol. Biol. Evol. 2013, 30, 2725–2729. [Google Scholar] [CrossRef] [Green Version]
- Silvestro, D.; Michalak, I. RaxmlGUI: A graphical front-end for RAxML. Org. Divers. Evol. 2012, 12, 335–337. [Google Scholar] [CrossRef]
- Dobretsov, S. Biofouling on artificial substrata in Muscat waters. J. Agric. Mar. Sci. JAMS 2015, 20, 24–29. [Google Scholar] [CrossRef] [Green Version]
- Chung, D.; Kim, H.; Choi, H.S. Fungi in salterns. J. Microbiol. Seoul Korea 2019, 57, 717–724. [Google Scholar] [CrossRef]
- Corinaldesi, C.; Barone, G.; Marcellini, F.; Dell’Anno, A.; Danovaro, R. Marine microbial-derived molecules and their potential use in cosmeceutical and cosmetic products. Mar. Drugs 2017, 15, 118. [Google Scholar] [CrossRef]
- Lee, Y.M.; Kim, M.J.; Li, H.; Zhang, P.; Bao, B.; Lee, K.J.; Jung, J.H. Marine-derived Aspergillus species as a source of bioactive secondary metabolites. Mar. Biotechnol. 2013, 15, 499–519. [Google Scholar] [CrossRef]
- Paulino, G.V.B.; Félix, C.R.; Landell, M.F. Diversity of filamentous fungi associated with coral and sponges in coastal reefs of northeast Brazil. J. Basic Microbiol. 2019, 60, 103–111. [Google Scholar] [CrossRef]
- Wang, G.; Li, Q.; Zhu, P. Phylogenetic diversity of culturable fungi associated with the Hawaiian sponges Suberites zeteki and Gelliodes fibrosa. Antonie Van Leeuwenhoek 2008, 93, 163–174. [Google Scholar] [CrossRef] [PubMed]
- Al-Shibli, H.; Dobretsov, S.; Al-Nabhani, A.; Maharachchikumbura, S.S.N.; Rethinasamy, V.; Al-Sadi, A.M. Aspergillus terreus obtained from mangrove exhibits antagonistic activities against Pythium aphanidermatum-induced damping-off of cucumber. PeerJ 2019, 7, e7884. [Google Scholar] [CrossRef] [Green Version]
- Halo, B.A.; Maharachchikumbura, S.S.N.; Al-Yahyai, R.A.; Al-Sadi, A.M. Cladosporium omanense, a new endophytic species from Zygophyllum coccineum in Oman. Phytotaxa 2019, 388, 145–154. [Google Scholar] [CrossRef]
- Tsang, C.-C.; Chan, J.F.W.; Pong, W.-M.; Chen, J.H.K.; Ngan, A.H.Y.; Cheung, M.; Lai, C.K.C.; Tsang, D.N.C.; Lau, S.K.P.; Woo, P.C.Y. Cutaneous hyalohyphomycosis due to Parengyodontium album gen. et comb. nov. Med. Mycol. 2016, 54, 699–713. [Google Scholar] [CrossRef] [Green Version]
- Ponizovskaya, V.B.; Rebrikova, N.L.; Kachalkin, A.V.; Antropova, A.B.; Bilanenko, E.N.; Mokeeva, V.L. Micromycetes as colonizers of mineral building materials in historic monuments and museums. Fungal Biol. 2019, 123, 290–306. [Google Scholar] [CrossRef]
- Khusnullina, A.I.; Bilanenko, E.N.; Kurakov, A.V. Microscopic fungi of White Sea sediments. Contemp. Probl. Ecol. 2018, 11, 503–513. [Google Scholar] [CrossRef]
- Zhao, D.-L.; Cao, F.; Wang, C.-Y.; Yang, L.-J.; Shi, T.; Wang, K.-L.; Shao, C.-L.; Wang, C.-Y. Alternatone A, an unusual perylenequinone-related compound from a soft-coral-derived strain of the fungus Alternaria alternata. J. Nat. Prod. 2019, 82, 3201–3204. [Google Scholar] [CrossRef]
- Chen, Y.; Chen, R.; Xu, J.; Tian, Y.; Xu, J.; Liu, Y. Two new altenusin/thiazole hybrids and a new benzothiazole derivative from the marine sponge-derived fungus Alternaria sp. SCSIOS02F49. Molecules 2018, 23, 2844. [Google Scholar] [CrossRef] [Green Version]
- Shi, Z.-Z.; Fang, S.-T.; Miao, F.-P.; Ji, N.-Y. Two new tricycloalternarene esters from an alga-epiphytic isolate of Alternaria alternata. Nat. Prod. Res. 2018, 32, 2523–2528. [Google Scholar] [CrossRef]
- Dobretsov, S.; Abed, R.M.M.; Muthukrishnan, T.; Sathe, P.; Al-Naamani, L.; Queste, B.Q.; Piontkovski, S. Living on the edge: Biofilms developing in oscillating environmental conditions. Biofouling 2018, 34, 1064–1077. [Google Scholar] [CrossRef]
- Rotini, A.; Tornambè, A.; Cossi, R.; Iamunno, F.; Benvenuto, G.; Berducci, M.T.; Maggi, C.; Thaller, M.C.; Cicero, A.M.; Manfra, L.; et al. Salinity-based toxicity of CuO nanoparticles, CuO-bulk and Cu ion to Vibrio anguillarum. Front. Microbiol. 2017, 8, 2076. [Google Scholar] [CrossRef]
- Nasrallah, D.A.; Morsi, M.A.; El-Sayed, F.; Metwally, R.A. Structural, optical and electrical properties of copper chloride filled polyvinyl chloride/polystyrene blend and its antifungal properties against Aspergillus avenaceus and Aspergillus terreus. Compos. Commun. 2020, 22. [Google Scholar] [CrossRef]
- Dias, M.A.; Lacerda, I.C.A.; Pimentel, P.F.; De Castro, H.F.; Rosa, C.A. Removal of heavy metals by an Aspergillus terreus strain immobilized in a polyurethane matrix. Lett. Appl. Microb. 2002, 34, 46–50. [Google Scholar] [CrossRef]
- Cervantes, C.; Gutierrez-Corona, F. Copper resistance mechanisms in bacteria and fungi. FEMS Microbiol. Rev. 1994, 14, 121–137. [Google Scholar] [CrossRef]
- Cappitelli, F.; Vicini, S.; Piaggio, P.; Abbruscato, P.; Princi, E.; Casadevall, A.; Nosanchuk, J.D.; Zanardini, E. Investigation of fungal deterioration of synthetic paint binders using vibrational spectroscopic techniques. Macromol. Biosci. 2005, 5, 49–57. [Google Scholar] [CrossRef]
- Saad, D.S.; Kinsey, G.C.; Kim, S.; Gaylarde, C.C. Extraction of genomic DNA from filamentous fungi in biofilms on water-based paint coatings; 12th International Biodeterioration and Biodegradation Symposium (Biosorption and Bioremediation III). Int. Biodeterior. Biodegrad. 2004, 54, 99–103. [Google Scholar] [CrossRef]
- Ogawa, N.; Okamura, H.; Hirai, H.; Nishida, T. Degradation of the antifouling compound Irgarol 1051 by manganese peroxidase from the white rot fungus Phanerochaete chrysosporium. Chemosphere 2004, 55, 487–491. [Google Scholar] [CrossRef] [Green Version]
- Bernat, P.; Długoński, J. Acceleration of tributyltin chloride (TBT) degradation in liquid cultures of the filamentous fungus Cunninghamella elegans. Chemosphere 2006, 62, 3–8. [Google Scholar] [CrossRef]
- Liu, L.L.; Wu, C.-H.; Qian, P.Y. Marine natural products as antifouling molecules—A mini-review (2014–2020). Biofouling 2020, 36, 1210–1226. [Google Scholar]
| Species | Substrate | No | GenBank Accession Number | Picture |
|---|---|---|---|---|
| Aspergillus tubingensis | Antifouling paint | H1 | MN947598 | ![]() |
| Aspergillus terreus | Antifouling paint | H2 | MN947599 | ![]() |
| Alternaria sp. | Antifouling paint | H3 | MN947600 | ![]() |
| Aspergillus niger | Antifouling paint | H4 | MN947601 | ![]() |
| Cladosporium halotolerans | Antifouling paint | H6 | MN947602 | ![]() |
| Cladosporium omanense | Antifouling paint | H7 | MN947603 | ![]() |
| Aspergillus pseudodeflectus | Not painted panel (control) | H90 | MN947605 | ![]() |
| Cladosporium omanense | Not painted panel (control) | H89 | MN947604 | ![]() |
| Cladosporium omanense | Ropes | H91 | MN947606 | ![]() |
| Parengyodontium album | Ropes | H92 | MN947607 | ![]() |
| Species | Substrate | Minimal Inhibitory Concentration |
|---|---|---|
| Aspergillus tubingensis | Antifouling paint | 4.3 |
| Aspergillus terreus | Antifouling paint | 5.2 |
| Alternaria sp. | Antifouling paint | 3.9 |
| Aspergillus niger | Antifouling paint | 4.3 |
| Cladosporium halotolerans | Antifouling paint | 3.9 |
| Cladosporium omanense | Antifouling paint | 1.3 |
| Aspergillus pseudodeflectus | Control | 0.17 |
| Cladosporium omanense | Control | 0.87 |
| Cladosporium omanense | Ropes | 1.3 |
| Parengyodontium album | Ropes | 1.3 |
Publisher’s Note: MDPI stays neutral with regard to jurisdictional claims in published maps and institutional affiliations. |
© 2021 by the authors. Licensee MDPI, Basel, Switzerland. This article is an open access article distributed under the terms and conditions of the Creative Commons Attribution (CC BY) license (https://creativecommons.org/licenses/by/4.0/).
Share and Cite
Dobretsov, S.; Al-Shibli, H.; Maharachchikumbura, S.S.N.; Al-Sadi, A.M. The Presence of Marine Filamentous Fungi on a Copper-Based Antifouling Paint. Appl. Sci. 2021, 11, 8277. https://doi.org/10.3390/app11188277
Dobretsov S, Al-Shibli H, Maharachchikumbura SSN, Al-Sadi AM. The Presence of Marine Filamentous Fungi on a Copper-Based Antifouling Paint. Applied Sciences. 2021; 11(18):8277. https://doi.org/10.3390/app11188277
Chicago/Turabian StyleDobretsov, Sergey, Hanaa Al-Shibli, Sajeewa S. N. Maharachchikumbura, and Abdullah M. Al-Sadi. 2021. "The Presence of Marine Filamentous Fungi on a Copper-Based Antifouling Paint" Applied Sciences 11, no. 18: 8277. https://doi.org/10.3390/app11188277
APA StyleDobretsov, S., Al-Shibli, H., Maharachchikumbura, S. S. N., & Al-Sadi, A. M. (2021). The Presence of Marine Filamentous Fungi on a Copper-Based Antifouling Paint. Applied Sciences, 11(18), 8277. https://doi.org/10.3390/app11188277